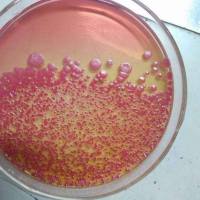
最小肉汤培养基说明书

万千商家帮你免费找货
0 人在求购买到急需产品
- 详细信息
- 询价记录
- 技术资料
- 库存:
59
- 英文名:
YPD Liquid Medium
- 保质期:
详见说明书
- 供应商:
上海一研
- 保存条件:
常温运输及保存
- 规格:
有效期两年
培养基按其物理状态可分为固体培养基、液体培养基和半固体培养基三类。
(1)固体培养基。是在培养基中加入凝固剂,有琼脂、明胶、硅胶等。固体培养基常用于微生物分离、鉴定、计数和菌种保存等方面。
用于微生物分离,鉴定,计数。如图,微生物分离成菌落、菌苔。图中为大肠杆菌菌落,是用涂布平板法得到。
用于分离微生物的固体培养基
用于分离微生物的固体培养基
(2)半固体培养基。产品仅限于科研是在液体培养基中加入少量凝固剂而呈半固体状态。可用于观察细菌的运动、鉴定菌种和测定噬菌体的效价等方面。
用于观察微生物运动特征。如图,左侧试管中微生物不运动,而右侧试管中微生物运动,因而两试管中现象不同
用于观察微生物运动特征的半固体培养基
用于观察微生物运动特征的半固体培养基
(3)液体培养基。液体培养基中不加任何凝固剂。这种培养基的成分均匀,微生物能充分接触和利用培养基中的养料,适于作生理等研究,由于发酵率高,操作方便,也常用于发酵工业。
订购信息:
中文名称:YPD液体培养基(YPD酵母培养基)
英文名称:YPD Liquid Medium
产品规格:250m
LYPD培养基又叫酵母浸出粉胨葡萄糖培养基,主要成分为Yeast Extract(酵母膏),Peptone(蛋白胨),Dextrose(glucose)(葡萄糖),为最常用的酵母培养基之一,本
储存条件:常温运输及保存,有效期两年。
按培养基组成物质的化学成分区分
根据对培养组成物质的化学成分是否完全了解来区分,可以将培养基分为天然培养基、合成培养基和半合成培养基。
(1)天然培养基。天然培养基是指利用各种动、植物或微生物的原料,其成分难以确切知道。例如培养细菌常用的肉汤蛋白胨培养基:牛肉膏3g,蛋白胨5g,水1000mL。
用做这种培养基的主要原料有:牛肉膏、麦芽汁、蛋白胨、酵母膏、玉米粉、麸皮、各种饼粉、马铃薯、牛奶、血清等。用这些物质配成的培养基虽然不能确切知道它的化学成分,但一般来讲,营养是比较丰富的,微生物生长旺盛,而且来源广泛,配制方便,所以较为常用,尤其适合于配制实验室常用的培养基和大上的培养基。
这种培养基的稳定性常受厂或批号等因素的影响,另外自养微生物一般不能在其上面生长。
(2)合成培养基。合成培养基是一类化学成分和数量完全知道的培养基,它是用已知化学成分的化学药品配制而成。例如培养细菌的葡萄糖铵盐培养基:C6H12O60.2%,K2HPO40.7%,KH2PO4 0.3%,Na3C6H5O70.05%,MgSO4·7H2O0.01%,(NH4)2SO40.1%,H2O 100mL。
这类培养基化学成分精确、重复性强,但价格昂贵,而微生物又生长缓慢,所以它只适用于做一些科学研究,例如营养、代谢的研究。
(3)半合成培养基。在合成培养基中,加入某种或几种天然成分;或者在天然培养基中,加入一种或几种已知成分的化学药品即成半合成培养基。例如马铃薯蔗糖培养基等。如果在合成培养基中加入琼脂,由于琼脂中含有较多的化学成分不太清楚的杂质,故也只能算是半合成培养基。这种培养基在实践和实验室中使用最多。
含量测定97%PYCARD ELISA Kit
英文名称:GADD153生长抑素受体2抗体
英文名称:GPR57生长抑素受体5抗体
英文名称:FRAT2突触结合蛋白相关基因2抗体
英文名称:phospho-gamma Adducin (Ser693)信号转导和转录激活因子2抗体
英文名称:GAPT干燥症SSB/La抗体
英文名称:GARNL3富含半胱氨酸的酸性分泌蛋白抗体
英文名称:GARNL1信号转导和转录激活因子3抗体爱普列特(标准品)DonkeyF(ab')2Anti-SheepIgGH&L(Phycoerythrin)preadsorbed
安倍生坦(标准品)Goatanti-RatIgGH&L(PE)Pre-Adsorbed
安乃近(标准品)Anti-BPhycoerythrinantibody
安替比林(标准品)GoatAnti-RabbitIgGH&L(Agarose)
氨蝶啶(标准品)GoatAnti-RatIgGH&L(Agarose)
氨砜(标准品)Anti-PRMT1antibody[MAT-B12]-ChIPGrade
氨苄西林/氨苄青霉素(标准品)Anti-HDAC1antibody-ChIPGrade
氨苄西林钠(标准品)Anti-HDAC2antibody-ChIPGrade
氨三醇(标准品)Anti-HDAC3antibody-ChIPGrade
氨芬酸钠(标准品)Anti-CollagenVantibody
比林(标准品)Anti-Nitrotyrosineantibody[HM.11]
己酸(标准品)GoatF(ab)Anti-RabbitIgGH&L(FITC)
三酸(标准品)GoatF(ab)Anti-RabbitIgGH&L(TRITC)
氨酸(标准品)GoatF(ab)Anti-RabbitIgGH&L(TexasRed®)
氨环酸(标准品)Anti-FactorVIIaantibody
YPD液体培养基(YPD酵母培养基)价格白花前胡进口/国产MEPE 细胞外质酸化抗体含量:Praeruptorin A
白花前胡进口/国产IFI44 干扰诱导蛋白44抗体含量:Praeruptorin C
贝母辛进口/国产KCNAB1/Kv beta 1 电压门控通道蛋白1抗体含量:Peimisine
地奥司明进口/国产Annexin II/Annexin A2 膜粘连蛋白 Ⅱ抗体含量:Diosimin
香蒲新苷进口/国产PRKD3 蛋白激酶C nu型抗体含量:Typhaneoside
哈巴俄苷进口/国产phospho-PRKD3(Ser41) 酸化蛋白激酶C nu型抗体含量:Harpagoside
哈巴苷进口/国产SLC30A3/ZNT3 溶质载体锌转运3抗体含量:Harpagide≥98%20mgplatelet factor 3,PF3 ELISA Kit
英文名称:EPO酸转运蛋白2抗体
英文名称:EPHX2溶质载体蛋白家族35成员C2抗体
英文名称:Estrogen Related Receptor gamma转绿激活蛋白SRCAP抗体
英文名称:Estrogen Related Receptor beta上皮特异性ETs转录因子抗体
英文名称:EMP2纤溶酶原激活物抑制因子2/血浆酶原激活酶抑制因子-2抗体
英文名称:ERG25SLFNL1抗体
英文名称:EST1ASCN2A抗体
培养基的保存时需注意:
YPD液体培养基(YPD酵母培养基)价格培养基应存放于冷暗处,建议存放于普通冰箱内。放置时间不宜超过一周,倾注的平板培养基不宜超过3天。每批培养基均必须附有该批培养基制各记录副页或明显标签。
产品仅限于科研培养基(Medium)是供微生物、植物和动物组织生长和维持用的人工配制的养料,一般都含有碳水化合物、含氮物质、无机盐(包括微量元素)以及维生素和水等。有的培养基还含有抗菌素和色素,用于单种微生物培养和鉴定。
培养基由于配制的原料不同,使用要求不同,而贮存保管方面也稍有不同。一般培养基在受热、吸潮后,易被细菌污染或分解变质,因此一般培养基必须防潮、避光、阴凉处保存。对一些需严格灭菌的培养基(如组织培养基),较长时间的贮存,必须放在2~6℃的冰箱内。由于液体培养基不易长期保管,现在均改制成粉末。
(1)固体培养基。是在培养基中加入凝固剂,有琼脂、明胶、硅胶等。固体培养基常用于微生物分离、鉴定、计数和菌种保存等方面。
用于微生物分离,鉴定,计数。如图,微生物分离成菌落、菌苔。图中为大肠杆菌菌落,是用涂布平板法得到。
用于分离微生物的固体培养基
用于分离微生物的固体培养基
(2)半固体培养基。产品仅限于科研是在液体培养基中加入少量凝固剂而呈半固体状态。可用于观察细菌的运动、鉴定菌种和测定噬菌体的效价等方面。
用于观察微生物运动特征。如图,左侧试管中微生物不运动,而右侧试管中微生物运动,因而两试管中现象不同
用于观察微生物运动特征的半固体培养基
用于观察微生物运动特征的半固体培养基
(3)液体培养基。液体培养基中不加任何凝固剂。这种培养基的成分均匀,微生物能充分接触和利用培养基中的养料,适于作生理等研究,由于发酵率高,操作方便,也常用于发酵工业。
订购信息:
| 产品名称 | YPD液体培养基(YPD酵母培养基)价格 |
| 英文名称 | YPD Liquid Medium |
| 货号 | EYJ6852 |
英文名称:YPD Liquid Medium
产品规格:250m
LYPD培养基又叫酵母浸出粉胨葡萄糖培养基,主要成分为Yeast Extract(酵母膏),Peptone(蛋白胨),Dextrose(glucose)(葡萄糖),为最常用的酵母培养基之一,本
储存条件:常温运输及保存,有效期两年。
按培养基组成物质的化学成分区分
根据对培养组成物质的化学成分是否完全了解来区分,可以将培养基分为天然培养基、合成培养基和半合成培养基。
(1)天然培养基。天然培养基是指利用各种动、植物或微生物的原料,其成分难以确切知道。例如培养细菌常用的肉汤蛋白胨培养基:牛肉膏3g,蛋白胨5g,水1000mL。
用做这种培养基的主要原料有:牛肉膏、麦芽汁、蛋白胨、酵母膏、玉米粉、麸皮、各种饼粉、马铃薯、牛奶、血清等。用这些物质配成的培养基虽然不能确切知道它的化学成分,但一般来讲,营养是比较丰富的,微生物生长旺盛,而且来源广泛,配制方便,所以较为常用,尤其适合于配制实验室常用的培养基和大上的培养基。
这种培养基的稳定性常受厂或批号等因素的影响,另外自养微生物一般不能在其上面生长。
(2)合成培养基。合成培养基是一类化学成分和数量完全知道的培养基,它是用已知化学成分的化学药品配制而成。例如培养细菌的葡萄糖铵盐培养基:C6H12O60.2%,K2HPO40.7%,KH2PO4 0.3%,Na3C6H5O70.05%,MgSO4·7H2O0.01%,(NH4)2SO40.1%,H2O 100mL。
这类培养基化学成分精确、重复性强,但价格昂贵,而微生物又生长缓慢,所以它只适用于做一些科学研究,例如营养、代谢的研究。
(3)半合成培养基。在合成培养基中,加入某种或几种天然成分;或者在天然培养基中,加入一种或几种已知成分的化学药品即成半合成培养基。例如马铃薯蔗糖培养基等。如果在合成培养基中加入琼脂,由于琼脂中含有较多的化学成分不太清楚的杂质,故也只能算是半合成培养基。这种培养基在实践和实验室中使用最多。
含量测定97%PYCARD ELISA Kit
英文名称:GADD153生长抑素受体2抗体
英文名称:GPR57生长抑素受体5抗体
英文名称:FRAT2突触结合蛋白相关基因2抗体
英文名称:phospho-gamma Adducin (Ser693)信号转导和转录激活因子2抗体
英文名称:GAPT干燥症SSB/La抗体
英文名称:GARNL3富含半胱氨酸的酸性分泌蛋白抗体
英文名称:GARNL1信号转导和转录激活因子3抗体爱普列特(标准品)DonkeyF(ab')2Anti-SheepIgGH&L(Phycoerythrin)preadsorbed
安倍生坦(标准品)Goatanti-RatIgGH&L(PE)Pre-Adsorbed
安乃近(标准品)Anti-BPhycoerythrinantibody
安替比林(标准品)GoatAnti-RabbitIgGH&L(Agarose)
氨蝶啶(标准品)GoatAnti-RatIgGH&L(Agarose)
氨砜(标准品)Anti-PRMT1antibody[MAT-B12]-ChIPGrade
氨苄西林/氨苄青霉素(标准品)Anti-HDAC1antibody-ChIPGrade
氨苄西林钠(标准品)Anti-HDAC2antibody-ChIPGrade
氨三醇(标准品)Anti-HDAC3antibody-ChIPGrade
氨芬酸钠(标准品)Anti-CollagenVantibody
比林(标准品)Anti-Nitrotyrosineantibody[HM.11]
己酸(标准品)GoatF(ab)Anti-RabbitIgGH&L(FITC)
三酸(标准品)GoatF(ab)Anti-RabbitIgGH&L(TRITC)
氨酸(标准品)GoatF(ab)Anti-RabbitIgGH&L(TexasRed®)
氨环酸(标准品)Anti-FactorVIIaantibody
YPD液体培养基(YPD酵母培养基)价格白花前胡进口/国产MEPE 细胞外质酸化抗体含量:Praeruptorin A
白花前胡进口/国产IFI44 干扰诱导蛋白44抗体含量:Praeruptorin C
贝母辛进口/国产KCNAB1/Kv beta 1 电压门控通道蛋白1抗体含量:Peimisine
地奥司明进口/国产Annexin II/Annexin A2 膜粘连蛋白 Ⅱ抗体含量:Diosimin
香蒲新苷进口/国产PRKD3 蛋白激酶C nu型抗体含量:Typhaneoside
哈巴俄苷进口/国产phospho-PRKD3(Ser41) 酸化蛋白激酶C nu型抗体含量:Harpagoside
哈巴苷进口/国产SLC30A3/ZNT3 溶质载体锌转运3抗体含量:Harpagide≥98%20mgplatelet factor 3,PF3 ELISA Kit
英文名称:EPO酸转运蛋白2抗体
英文名称:EPHX2溶质载体蛋白家族35成员C2抗体
英文名称:Estrogen Related Receptor gamma转绿激活蛋白SRCAP抗体
英文名称:Estrogen Related Receptor beta上皮特异性ETs转录因子抗体
英文名称:EMP2纤溶酶原激活物抑制因子2/血浆酶原激活酶抑制因子-2抗体
英文名称:ERG25SLFNL1抗体
英文名称:EST1ASCN2A抗体
培养基的保存时需注意:
YPD液体培养基(YPD酵母培养基)价格培养基应存放于冷暗处,建议存放于普通冰箱内。放置时间不宜超过一周,倾注的平板培养基不宜超过3天。每批培养基均必须附有该批培养基制各记录副页或明显标签。
产品仅限于科研培养基(Medium)是供微生物、植物和动物组织生长和维持用的人工配制的养料,一般都含有碳水化合物、含氮物质、无机盐(包括微量元素)以及维生素和水等。有的培养基还含有抗菌素和色素,用于单种微生物培养和鉴定。
培养基由于配制的原料不同,使用要求不同,而贮存保管方面也稍有不同。一般培养基在受热、吸潮后,易被细菌污染或分解变质,因此一般培养基必须防潮、避光、阴凉处保存。对一些需严格灭菌的培养基(如组织培养基),较长时间的贮存,必须放在2~6℃的冰箱内。由于液体培养基不易长期保管,现在均改制成粉末。
风险提示:丁香通仅作为第三方平台,为商家信息发布提供平台空间。用户咨询产品时请注意保护个人信息及财产安全,合理判断,谨慎选购商品,商家和用户对交易行为负责。对于医疗器械类产品,请先查证核实企业经营资质和医疗器械产品注册证情况。
- 作者
- 内容
- 询问日期
技术资料暂无技术资料 索取技术资料
YPD液体培养基(YPD酵母培养基)价格
询价